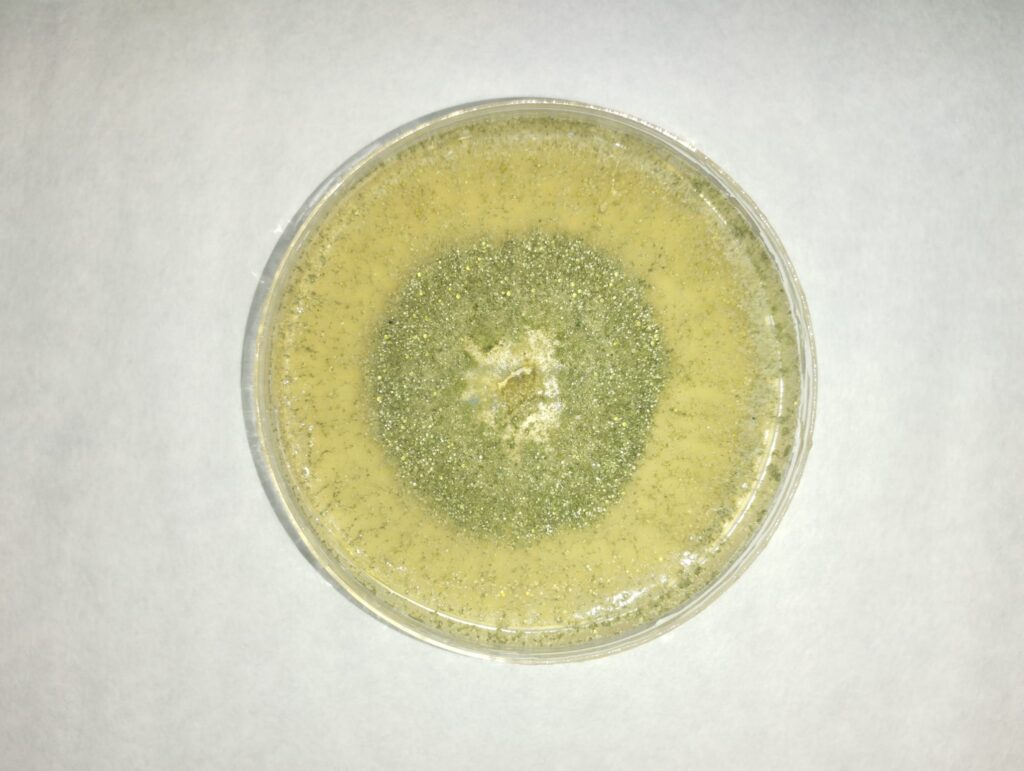
trichoderma

Water is Essential: Enhancing Its Management Through Biostimulant Solutions

ON MARCH 22, WE ONCE AGAIN COMMEMORATED WORLD WATER DAY, AND ON MARCH 26, WORLD CLIMATE DAY, TWO OBSERVANCES THAT, UNFORTUNATELY, SERVE AS REMINDERS OF JUST HOW URGENT IT IS TO ADDRESS CLIMATE-RELATED CHALLENGES IN TODAY’S CONTEXT.
Frost: how to protect our crops from low temperatures

The intracellular and extracellular ice that forms as a consequence of frost endangers the integrity of plant cells and can even cause their death.
Microorganism-Based Biostimulants: More and Better Every Day

Microorganism-based biostimulants are more than just a short-term solution. In fact, they are a key element in moving towards a more resilient, efficient, and environmentally friendly agriculture.
We are launching 𝗠𝗬𝗖𝗢𝗕𝗥𝗢𝗪, our innovative biostimulant made from olive tree waste

MAFA’s new biosolution is now CE certified, confirming its proven benefits for broad-acre crops, perennial woody species, and horticultural crops.
5 biostimulant effects of the Ecklonia Maxima algae

We often talk about seaweed, because of its usefulness in the formulation of agricultural biostimulants. And today we are talking about the Ecklonia maxima algae, as it is used to produce soluble natural biosolutions that promote the development and yield of crops. Precisely for this reason we chose the Ecklonia maxima extract to produce Eklobac, […]
The effectiveness of Indumax against the Verticillium fungus in eggplant crops

Eggplant cultivation is very sensitive to the Verticillium, a fungus that penetrates through the roots and affects the transit of the sap, causing wilting and desiccation. With special incidence in solanaceae such as eggplant, tomato or bell pepper, it weakens plants to the point of considerably reducing crop yields or, in the worst cases, causing […]
THE BIOSTIMULANT PROPERTIES OF THE TRICHODERMA FUNGI
You already know that we never tire of saying that the soil is full of life. Beneficial life in many cases for the health of the crops and, therefore, for their performance. Well, today we want to give you some interesting facts about the fungus Trichoderma harzianum, which is one of the most common microorganisms […]